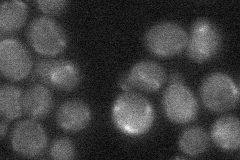

View description
Protein that acts together with Ula1p to activate Rub1p before its conjugation to proteins (neddylation), which may play a role in protein degradation; GFP-fusion protein localizes to the cytoplasm in a punctate pattern
Localization:
Intensity:
Fold change:
Significance:
-
C’ GFP library in SD

below threshold16.51 -
N' NOP1pr-GFP in SD

cytosol36.0425 -
N' TEF2pr-mCherry in SD

nucleus27.1179 -
N' NATIVEpr-GFP in SD
below threshold19.3671 -
N' TEF2pr-VC and Cyto-VN in SD

cytosol29.0257 -
C’ GFP library in SD+DTT

cytosol16.991.02No -
C’ GFP library in SD+H2O2

cytosol17.481.05No -
C’ GFP library in Starvation Media

cytosolN/AN/AYes -
C’ GFP library on the background of Pup2-DaMP

below threshold -
C’ GFP library on the background of CCT mutant

below threshold16.61081.00525No
